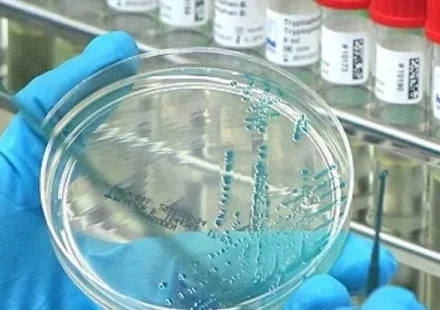

SpaceX впервые отправит людей в полярный полет вокруг Земли
12 августа компания SpaceX неожиданно объявила о новой космической миссии с участием частных астронавтов, целью которой станет доставка четырех пассажиров на полярную орбиту вокруг Земли в капсуле Dragon. Это будет первая в истории экспедиция с людьми на…
Читать далееВИЧ: новый вариант, обнаруженный в Нидерландах, удивляет исследователей
Фото: Artem_Egorov / iStock[/caption] Недавнее исследование, проведенное почти в десяти странах, выявило появление нового варианта ВИЧ более чем у ста пациентов. Этот вариант более вирулентен и более трансмиссивен, чем другие, что позволяет болезни…
Читать далееВ докладе ООН говорится, что почти половина мигрирующих видов в мире находится в упадке
Каждый год, когда сменяются времена года, миллиарды животных отправляются в путешествия, чтобы найти пищу, добраться до лучших мест обитания или вывести потомство. Они мигрируют группами и поодиночке, летают, плавают, ползают и ходят через международные…
Читать далееМарсоход прислал первый снимок после посадки
Сделано! НАСА только что объявило, что марсоход Perseverance успешно приземлился в кратере Езеро, совершив новый невероятный подвиг! 30 июля прошлого года была запущена миссия NASA Марс-2020. Ее цель: высадить марсоход Perseverance на поверхность Марса.…
Читать далееПтичий грипп в США: первый летальный случай зарегистрирован в Луизиане
В штате Луизиана зарегистрирован первый в США случай смерти человека от вируса птичьего гриппа H5N1. По данным департамента здравоохранения Луизианы, пациенту было более 65 лет, и он имел сопутствующие заболевания, что повышало риск тяжелого течения…
Читать далееВсего 3 дня чрезмерного употребления алкоголя вызывают быстрое повреждение кишечника у мышей
Новое исследование на мышах демонстрирует, что даже кратковременный период чрезмерного употребления алкоголя может нанести быстрый и значительный ущерб кишечнику. Ранее было известно, что хроническое злоупотребление спиртным нарушает микрофлору и…
Читать далееПервый корейский зонд вышел на орбиту Луны
Космический аппарат «Данури» вышел на лунную орбиту в пятницу 16 декабря после четырехмесячного путешествия в космосе. Эта миссия знаменует собой начало инициативы Южной Кореи по исследованию дальнего космоса. Цель аппарата — исследовать…
Читать далееРанняя Вселенная: как появились первые сверхмассивные звезды
Используя возможности телескопа Джеймса Уэбба, группа исследователей обнаружила несколько сверхмассивных звезд в самой ранней Вселенной. Родившиеся всего через 440 миллионов лет после Большого взрыва, эти «небесные монстры» могут пролить свет…
Читать далееПрорыв в лечении рака прямой кишки: новое лекарство
html Копировать Скачать Запустить Представьте: вы приходите к онкологу, а он говорит, что рак можно просто… убрать. Без скальпеля, без химии, без облучения. Звучит как фантастика из далекого будущего, правда? А вот и нет. Будущее уже наступило, и имя ему…
Читать далееВпервые составлена молекулярная карта зоны рождения планет
Связь между составом планет и местом их формирования была изучена благодаря ALMA. Исследовательская группа разработала карту химического состава околозвездных дисков пяти близлежащих звезд, определив связь между молекулами и рождением планет. MAPS…
Читать далееЧто убивает и спасает ваш микробиом
Знаете это чувство, когда вы не одни в комнате, но точно знаете, что кто-то есть? Так вот, прямо сейчас, читая эти строки, вы в компании. И компания эта немалая — триллионы микроорганизмов обосновались на вашей коже, в кишечнике и где только можно. Не…
Читать далееStarship успешно стартовал в шестом испытательном полете
Компания SpaceX завершила шестой полет мега-ракеты Starship 19 ноября 2024 года, укрепив свои позиции в качестве основного игрока в освоении космоса. По мере того как эта революционная ракета приближается к переходу к оперативным полетам, главный…
Читать далееВ бразильских лесах обнаружена миниатюрная жаба размером с кончик карандаша
Учёные обнаружили в Бразилии новый вид миниатюрных жаб, отличающийся яркой оранжевой окраской. Открытие было сделано в сырой подстилке листьев Атлантического леса. Почти невесомая амфибия, размер которой сравним с кончиком карандаша, получила научное…
Читать далееНа «крыше мира» строят телескоп для разгадки тайн Вселенной
Китай приступил к строительству крупного астрономического проекта на Цинхай-Тибетском нагорье, которое стартовало в субботу. Цель проекта заключается в расширении возможностей страны по исследованию холодной и скрытой Вселенной за счет создания…
Читать далее